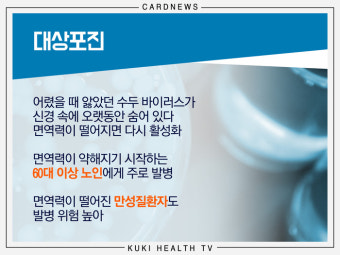

나이가 들수록 면역력이 서서히 약해지면서 젊을 때는 대수롭지 않게 지나갔던 바이러스가 큰 고통을 주기도 합니다. 그 대표적인 사례가 바로 대상포진입니다. 특히 50대 이후부터는 발병 위험이 급격히 올라가기 때문에 많은 사람들이 실제로 겪고 나서야 그 고통을 체감합니다. 이번 글에서는 대상포진 증상, 치료 방법, 그리고 왜 50대 이상에게는 예방접종이 필수적인지를 정리해 보겠습니다.

대상포진이란 무엇인가?
대상포진은 어릴 적 앓았던 수두 바이러스가 몸속 신경절에 숨어 있다가, 면역력이 약해지는 시기에 다시 활성화되면서 생기는 질환입니다. 피부에 물집이 잡히고 신경통을 동반하는데, 단순한 피부 질환이 아니라 신경계에 영향을 주는 질환이라는 점이 무섭습니다.
(1) 잠복기 : 수두를 앓은 뒤 바이러스가 몸속에 수십 년간 숨어 있음
(2) 발병 요인 : 면역력 저하, 과도한 스트레스, 고령, 만성질환 등
(3) 특징 : 피부 발진과 심한 통증이 신경을 따라 띠 모양으로 나타남
대상포진의 대표적인 증상
대상포진 증상은 단순히 피부에 물집이 생기는 것에 그치지 않습니다. 발병 초기에는 감기처럼 몸살 기운이 오기도 하며, 이후에는 극심한 통증이 동반됩니다.
(1) 초기 증상 : 몸이 으슬으슬 춥거나, 두통·피로감이 동반됨
(2) 대표 증상
피부 발진과 물집 (주로 몸통, 얼굴, 허리 주변)
칼로 베는 듯한 신경통
접촉만 해도 심한 통증을 유발하는 과민 반응
(3) 합병증 : 포진 후 신경통이 수개월~수년간 지속될 수 있음
특히 50대 이상에서는 포진 후 신경통(Postherpetic Neuralgia) 발생률이 높아, 단순한 피부 질환을 넘어 삶의 질을 심각하게 떨어뜨리는 원인이 됩니다.


대상포진 치료방법
대상포진은 발병 초기에 치료를 시작하는 것이 무엇보다 중요합니다. 증상이 나타난 지 72시간 이내에 항바이러스제를 복용하면 회복 속도가 빨라지고 합병증 위험이 줄어듭니다.
(1) 항바이러스제 : 바이러스 증식을 억제, 초기 치료의 핵심
(2) 진통제 및 신경 차단제 : 통증 완화를 위한 보조 치료
(3) 피부 관리 : 물집이 터지지 않도록 관리하고, 2차 감염 예방
(4) 입원 치료 : 눈 주변이나 뇌신경에 영향을 줄 경우 필요
많은 환자들이 약을 늦게 먹어서 통증이 오래가는데, 증상이 의심되면 지체 없이 치료를 시작하는 것이 가장 좋은 방법입니다.
50대 이상에게 예방접종이 필수인 이유
50대가 되면 면역력이 서서히 떨어지면서 대상포진 발병률이 크게 증가합니다. 실제로 통계적으로도 50대 이상에서 환자 수가 가장 많고, 60대 이후에는 합병증 발생률이 급격히 올라갑니다. 예방접종이 필수적인 이유는 다음과 같습니다.
(1) 발병률 감소 : 예방접종을 하면 대상포진 발병 위험이 절반 이하로 줄어듭니다.
(2) 합병증 예방 : 포진 후 신경통 같은 고통스러운 합병증 가능성을 크게 낮춰줍니다.
(3) 노후 건강 관리 : 은퇴 후 삶의 질을 지키기 위해 필수적인 자기방어 수단입니다.
(4) 경제적 이득 : 치료 비용과 장기간의 신경통 치료비를 고려하면 예방이 훨씬 저렴합니다.
특히 당뇨, 고혈압, 심혈관 질환 같은 만성질환을 앓은 50대 이상이라면 면역력이 더 약해져 있기 때문에 예방접종이 사실상 필수라고 볼 수 있습니다.
경험담에서 배우는 교훈
실제로 많은 50대, 60대 환자들이 “처음에는 단순한 피부 발진인 줄 알았다가, 나중에 대상포진이라는 진단을 받고 너무 늦게 치료를 시작했다”라는 이야기를 합니다. 한 번 겪어본 사람들은 “그 고통은 다시는 경험하고 싶지 않다”며 주변 사람들에게 꼭 예방접종을 권유하곤 합니다.


대상포진 예방이 최선의 치료
대상포진은 치료도 가능하지만, 예방접종만큼 확실한 방법은 없습니다. 특히 50대 이후에는 발병 위험과 합병증 가능성이 동시에 높아지므로, 지금까지 건강에 자신이 있었던 사람이라도 예방을 서두르는 것이 좋습니다.
(1) 대상포진 증상은 피부 발진과 극심한 신경통
(2) 치료 방법은 조기 항바이러스제 복용이 핵심
(3) 50대 이상 예방접종 필수 이유는 발병률과 합병증 위험이 크기 때문
건강은 잃고 나서 후회하기보다, 미리 준비하는 것이 훨씬 현명합니다. 대상포진 역시 마찬가지입니다. 특히 50대 이상이라면 예방접종을 통해 불필요한 고통을 줄이고, 건강한 노후를 준비하는 것이 가장 큰 투자라고 할 수 있습니다.
